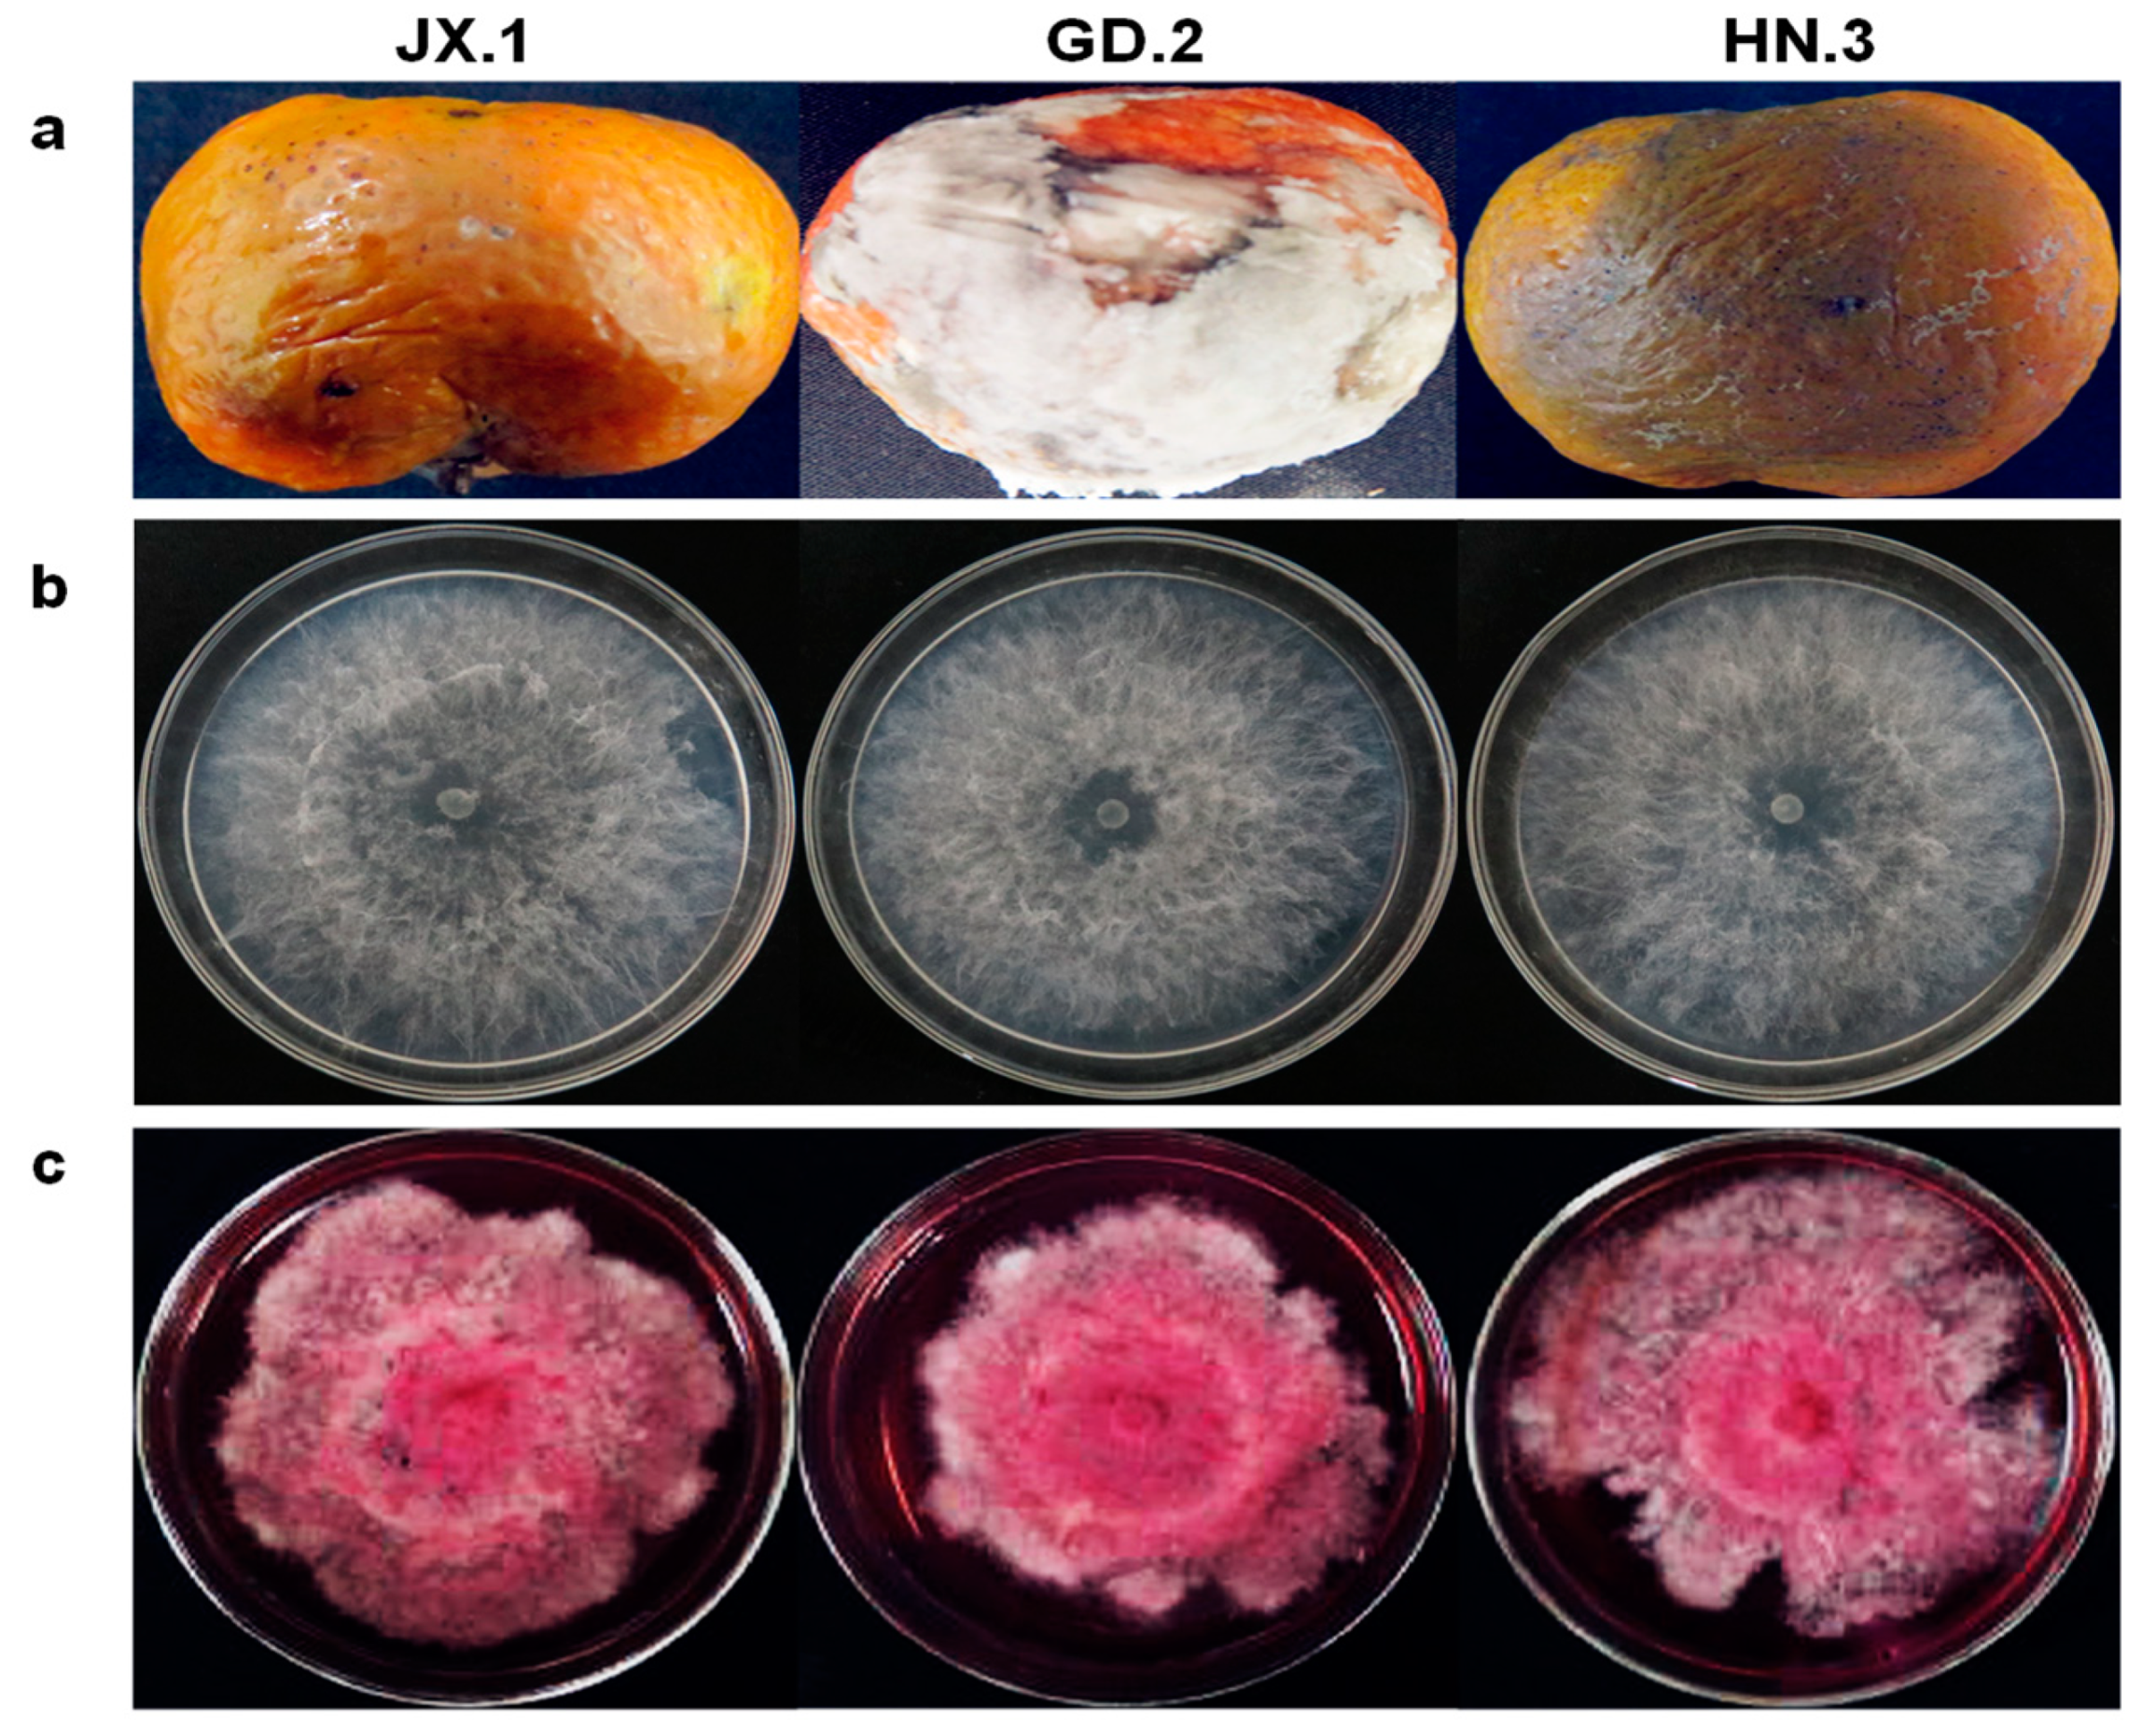
Plants 10 00202 g001 Plants 10 00202 g001

Identification of Lasiodiplodia pseudotheobromae Causing Fruit Rot of Citrus in China
Abstract
1. Introduction
2. Results
2.1. Fungal Isolates
2.2. Molecular Characterization
2.3. Morphological Characteristics
2.4. Pathogenicity Assay
3. Discussion
4. Materials and Methods
4.1. Fungal Isolates
4.2. Molecular Characterization
4.3. Phylogenetic Analysis
4.4. Morphological Characterization
4.5. Pathogenicity Assay
Supplementary Materials
Author Contributions
Funding
Institutional Review Board Statement
Informed Consent Statement
Data Availability Statement
Conflicts of Interest
References
- Deng, X.X.; Peng, C.J.; Chen, Z.S.; Deng, Z.N.; Xu, J.G.; Li, J. Citrus Varieties in China; China Agriculture Press: Beijing, China, 2008. [Google Scholar]
- FAO. Citrus Fruit—Fresh and Processed Statistical Bulletin 2016; Food and Agriculture Organization of the United Nations: Rome, Italy, 2017. [Google Scholar]
- Salunkhe, D.K.; Bolin, H.R.; Reddy, N.R. Storage, Processing, and Nutritional Quality of Fruits and Vegetables, 2nd ed.; CRC Press: Boca Raton, FL, USA, 1991. [Google Scholar]
- Punithalingam, E. Plant Diseases Attributed to Botryodiplodia Theobromae Pat; Cramer: Vaduz, Liechtenstein, 1980. [Google Scholar]
- Alves, A.; Crous, P.W.; Correia, A.; Phillips, A.J.L. Morphological and molecular data reveal cryptic speciation in Lasiodiplodia theobromae. Fungal Divers. 2008, 28, 1–13. [Google Scholar]
- Phillips, A.J.L.; Alves, A.; Abdollahzadeh, J.; Slippers, B.; Wingfield, M.J.; Groenewald, J.Z.; Crous, P.W. The Botryosphaeriaceae: Genera and species known from culture. Stud. Mycol. 2013, 76, 51–167. [Google Scholar] [CrossRef] [PubMed]
- Abdollahzadeh, J.; Javadi, A.; Goltapeh, E.M.; Zare, R.; Phillips, A.J.L. Phylogeny and morphology of four new species of Lasiodiplodia from Iran. Persoonia 2010, 25, 1–10. [Google Scholar] [CrossRef]
- Begoude, B.A.D.; Slippers, B.; Wingfield, M.J.; Roux, J. Botryosphaeriaceae associated with Terminalia catappa in Cameroon, South Africa and Madagascar. Mycol. Prog. 2010, 9, 101–123. [Google Scholar] [CrossRef]
- Correia, K.C.; CÂMara, M.P.S.; Barbosa, M.A.G.; Sales, R.; AgustÍ-Brisach, C.; Gramaje, D.; LeÓN, M.; GarcÍA-JimÉNez, J.; Abad-Campos, P.; Armengol, J.; et al. Fungal trunk pathogens associated with table grape decline in North-eastern Brazil. Phytopathol. Mediterr. 2013, 52, 380–387. [Google Scholar]
- Dissanayake, A.J.; Zhang, W.; Mei, L.; Chukeatirote, E.; Yan, J.Y.; Li, X.; Hyde, K.D. Lasiodiplodia pseudotheobromae causes pedicel and peduncle discolouration of grapes in China. Australas. Plant Dis. Notes 2015, 10, 21. [Google Scholar] [CrossRef]
- Ismail, A.M.; Cirvilleri, G.; Polizzi, G.; Crous, P.W.; Groenewald, J.Z.; Lombard, L. Lasiodiplodia species associated with dieback disease of mango (Mangifera indica) in Egypt. Australas. Plant Pathol. 2012, 41, 649–660. [Google Scholar] [CrossRef]
- Kwon, J.-H.; Choi, O.; Kang, B.; Lee, Y.; Park, J.; Kang, D.-W.; Han, I.; Kim, J. Identification of Lasiodiplodia pseudotheobromae causing mango dieback in Korea. Can. J. Plant Pathol. 2017, 39, 241–245. [Google Scholar] [CrossRef]
- Li, G.Q.; Liu, F.F.; Li, J.Q.; Liu, Q.L.; Chen, S.F. Botryosphaeriaceae from Eucalyptus plantations and adjacent plants in China. Persoonia 2018, 40, 63–95. [Google Scholar] [CrossRef]
- Netto, M.S.B.; Assunção, I.P.; Lima, G.S.A.; Marques, M.W.; Lima, W.G.; Monteiro, J.H.A.; de Queiroz Balbino, V.; Michereff, S.J.; Phillips, A.J.L.; Câmara, M.P.S. Species of Lasiodiplodia associated with papaya stem-end rot in Brazil. Fungal Divers. 2014, 67, 127–141. [Google Scholar] [CrossRef]
- Netto, M.S.B.; Lima, W.G.; Correia, K.C.; da Silva, C.F.B.; Thon, M.; Martins, R.B.; Miller, R.N.G.; Michereff, S.J.; Câmara, M.P.S. Analysis of phylogeny, distribution, and pathogenicity of Botryosphaeriaceae species associated with gummosis of Anacardium in Brazil, with a new species of Lasiodiplodia. Fungal Biol. 2017, 121, 437–451. [Google Scholar] [CrossRef] [PubMed]
- Pillay, K.; Slippers, B.; Wingfield, M.J.; Gryzenhout, M. Diversity and distribution of co-infecting Botryosphaeriaceae from Eucalyptus grandis and Syzygium cordatum in South Africa. S. Afr. J. Bot. 2013, 84, 38–43. [Google Scholar] [CrossRef]
- Pipattanapuckdee, A.; Boonyakait, D.; Tiyayon, C.; Seehanam, P.; Ruangwong, O.-U. Lasiodiplodia pseudotheobromae causes postharvest fruit rot of longan in Thailand. Australas. Plant Dis. Notes 2019, 14, 21. [Google Scholar] [CrossRef]
- Trakunyingcharoen, T.; Lombard, L.; Groenewald, J.Z.; Cheewangkoon, R.; To-anun, C.; Crous, P.W. Caulicolous Botryosphaeriales from Thailand. Persoonia 2015, 34, 87–99. [Google Scholar] [CrossRef] [PubMed]
- de Silva, N.I.; Phillips, A.J.L.; Liu, J.-K.; Lumyong, S.; Hyde, K.D. Phylogeny and morphology of Lasiodiplodia species associated with Magnolia forest plants. Sci. Rep. 2019, 9, 14355. [Google Scholar] [CrossRef]
- Sultana, R.; Islam, M.S.; Rahman, H.; Alam, M.S.; Islam, M.A.; Sikdar, B. Characterization of Lasiodiplodia pseudotheobromae associated with citrus stem-end rot disease in Bangladesh. Int. J. Biosci. 2018, 13, 252–262. [Google Scholar]
- Awan, Q.N.; Akgül, D.S.; Unal, G. First Report of Lasiodiplodia pseudotheobromae Causing Postharvest Fruit Rot of Lemon in Turkey. Plant Dis. 2016, 100, 2327. [Google Scholar] [CrossRef]
- Zhao, J.P.; Liang, Q.; Lu, Q.; Zhang, X.Y. Lasiodiplodia pseudotheobromae a new record of pathogenic fungus from some subtropical and tropical trees in southern China. Cryptogam. Mycol. 2010, 31, 431–439. [Google Scholar]
- Feng, L.; Qu, Z.; Cheng, J.S.; Xie, J.T.; Fu, Y.P.; Guo, D.Y. First Report of Postharvest Rot Caused by Rhizopus oryzae of Kiwifruit in Shandong Province, China. Plant Dis. 2019, 103, 2951. [Google Scholar] [CrossRef]
- Sambrook, J.; Fritsch, E.F.; Maniatis, T. Molecular Cloning: A Laboratory Manual, 2nd ed.; Cold Spring Harbor Laboratory: Cold Spring Harbor, NY, USA, 1989. [Google Scholar]
- Glass, N.L.; Donaldson, G.C. Development of primer sets designed for use with the PCR to amplify conserved genes from filamentous ascomycetes. Appl. Environ. Microbiol. 1995, 61, 1323. [Google Scholar] [CrossRef]
- White, T.J.; Bruns, T.; Lee, S.; Taylor, J. Amplification and direct sequencing of fungal ribosomal RNA genes for phylogenetics. In PCR Protocols: A Guide to Methods and Applications; Innis, M.A., Gelfand, D.H., Sninsky, J.J., White, T.J., Eds.; Academic Press: San Diego, CA, USA, 1990; pp. 315–322. [Google Scholar]
- Hall, A.T. BioEdit: A user-friendly biological sequence alignment editor and analysis program for Windows 95/98/NT. Nucleic Acids Res. 1999, 41, 95–98. [Google Scholar]
- Katoh, K.; Rozewicki, J.; Yamada, K.D. MAFFT online service: Multiple sequence alignment, interactive sequence choice and visualization. Brief. Bioinform. 2017, 20, 1160–1166. [Google Scholar] [CrossRef] [PubMed]
- Stamatakis, A. RAxML version 8: A tool for phylogenetic analysis and post-analysis of large phylogenies. Bioinformatics 2014, 30, 1312–1313. [Google Scholar] [CrossRef] [PubMed]
- Swofford, D.L. PAUP* Phylogenetic Analysis Using Parsimony, (*and other Methods); Version 4.0 b10; Sinauer Associates: Sunderland, MA, USA, 2003. [Google Scholar]

| Citrus Varieties | Location | Lasiodiplodia Strain | No. of Rotten Fruit Except for Those with Green and Blue Mold Symptoms | Total No. of Investigated Fruit | Incidence (%) |
|---|---|---|---|---|---|
| Citrus unshiu | Guangxi, Guilin | 1 | 27 | 225 | 0.44 |
| Hunan, Huaihua | 5 | 76 | 320 | 1.56 | |
| Hubei, Wuhan | 1 | 69 | 258 | 0.39 | |
| Hubei, Yicang | 1 | 18 | 344 | 0.29 | |
| Zhejiang, Taizhou | 2 | 20 | 259 | 0.77 | |
| Citrus reticulata Blanco cv. Ponkan | Fujiang, Quanzhou | 1 | 7 | 92 | 1.09 |
| Citrus reticulata cv. nanfengmiju | Jiangxi, Nanfeng | 3 | 111 | 566 | 0.53 |
| Citrus reticulata Blanco | Guangdong, Quangzhou | 2 | 74 | 338 | 0.59 |
Publisher’s Note: MDPI stays neutral with regard to jurisdictional claims in published maps and institutional affiliations. |
© 2021 by the authors. Licensee MDPI, Basel, Switzerland. This article is an open access article distributed under the terms and conditions of the Creative Commons Attribution (CC BY) license (http://creativecommons.org/licenses/by/4.0/).
Share and Cite
Chen, J.; Zhu, Z.; Fu, Y.; Cheng, J.; Xie, J.; Lin, Y. Identification of Lasiodiplodia pseudotheobromae Causing Fruit Rot of Citrus in China. Plants 2021, 10, 202. https://doi.org/10.3390/plants10020202
Chen J, Zhu Z, Fu Y, Cheng J, Xie J, Lin Y. Identification of Lasiodiplodia pseudotheobromae Causing Fruit Rot of Citrus in China. Plants. 2021; 10(2):202. https://doi.org/10.3390/plants10020202
Chicago/Turabian StyleChen, Jianghua, Zihang Zhu, Yanping Fu, Jiasen Cheng, Jiatao Xie, and Yang Lin. 2021. "Identification of Lasiodiplodia pseudotheobromae Causing Fruit Rot of Citrus in China" Plants 10, no. 2: 202. https://doi.org/10.3390/plants10020202
APA StyleChen, J., Zhu, Z., Fu, Y., Cheng, J., Xie, J., & Lin, Y. (2021). Identification of Lasiodiplodia pseudotheobromae Causing Fruit Rot of Citrus in China. Plants, 10(2), 202. https://doi.org/10.3390/plants10020202

